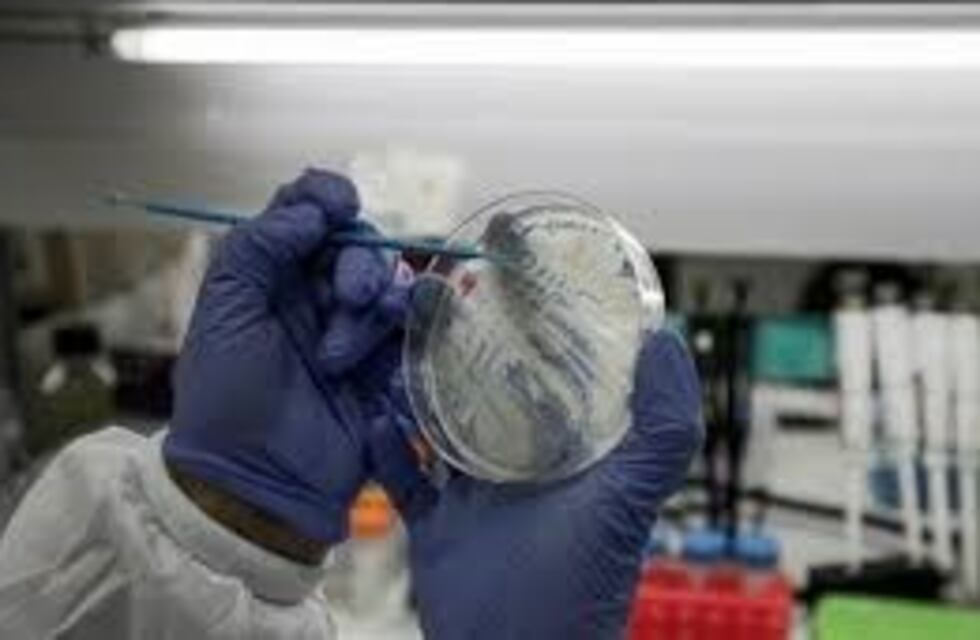

En un comunicado, José Bría, intendente de la localidad de Morteros, al medio de comunicación Cadena 3, dijo que la desición de aislar a 27 personas, se debe a que habrían estado en contacto directo con el paciente infectado. El hombre contrajo la enfermedad en Italia, actualmente está apartado en un departamento de Córdoba.
En la ciudad, el Intendente recalcó que están interviniendo sobre la problemática de salud, bajo el protocolo del Ministerio de Salud de la Provincia. Con respecto a la manera de proceder, señaló que durante todo el día de ayer domingo 8 de marzo, evaluaron, junto al equipo técnico de epidemiología, los sitios sanitarios. Dieron con 27 personas que habrían estado en contacto directo con el infectado, por lo que permanecen aisladas en sus casas.
El intendente explicó que la mayor parte de los aislados son del sector de salud, los demás serían familiares. De las 27 personas, 4 presentaron síntomas específicos, luego de el análisis pertinente, los resultados fueron negativos. No obstante, las actividades de educación, salud, deportes, trabajo, entre otras areas, funcionan normalmente en la comunidad.
Se recomienda desde el Municipio de Morteros, que quienes manifiesten fiebre, solores articulares y anomalías respiratorias, deben consultar inmediatamente con un médico.